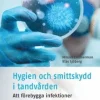
Hygien och smittskydd i tandvården : att förebygga infektioner

Hygien och smittskydd i tandvården : att förebygga infektioner
kr466.44 Original price was: kr466.44.kr333.50Current price is: kr333.50.
SKU: SKUzEasXiLPOY Categories: Ämnen A-Ö, Böcker, Vetenskap & Teknik
Boken Hygien och smittskydd i tandvården av Mikael Zimmerman och Klas Sjöberg ger såväl bakgrundskunskaper som praktiska kunskaper om mikroorganismer, smittskydd, hygienrutiner och smittreningsprocesser. Här beskrivs också korrekt hantering av medicinska och kirurgiska instrument. Boken avslutas med en Snabbguide, en uppslagsdel specifikt avsedd för tandvården. Den förklarar ord och begrepp samt ger korta svar på hur olika artiklar ska smittrenas, desinfekteras och steriliseras. Genomtänkta hygienrutiner förenklar vardagsarbetet, förbättrar vårdekonomin och bidrar till ökad patientsäkerhet. Att följa basala hygienrutiner är dessutom en absolut nödvändighet för att bromsa utvecklingen av antibiotikaresistens hos mikroorganismer. Därför är boken Hygien och smittskydd i tandvården så viktig. Nytt i denna kraftigt omarbetade och utökade upplaga är avsnitt om vägledning till praktisk klinisk infektionsmedicin vid patientbehandling samt kapitel om aspekter kring personalsäkerhet. Boken vänder sig till studerande på tandvårdsutbildningarna och till yrkesverksamma inom tandvården, men kan också användas inom andra verksamheter där hygien och smittskydd är viktigt. Observera att innehållet i denna bok är identiskt med föregående upplaga.
- Författare: Mikael Zimmerman, Klas Sjöberg
- Format: Häftad
- ISBN: 9789177415268
- Språk: Svenska
- Antal sidor: 256
- Utgivningsdatum: 2025-01-07
- Förlag: Gothia Kompetens AB
Be the first to review “Hygien och smittskydd i tandvården : att förebygga infektioner” Avbryt svar
Related products
Ämnen A-Ö
kr131.72
Ämnen A-Ö
kr90.14
Ämnen A-Ö
kr131.72
Sale!
Ämnen A-Ö
kr130.70
Ämnen A-Ö
kr689.42
Ämnen A-Ö
kr344.66
Sale!
Ämnen A-Ö
Ämnen A-Ö
kr171.26
Sale!
Ämnen A-Ö
Ämnen A-Ö
kr91.16
Sale!
Ämnen A-Ö
Sale!
Ämnen A-Ö
Ämnen A-Ö
kr293.96

Reviews
There are no reviews yet.